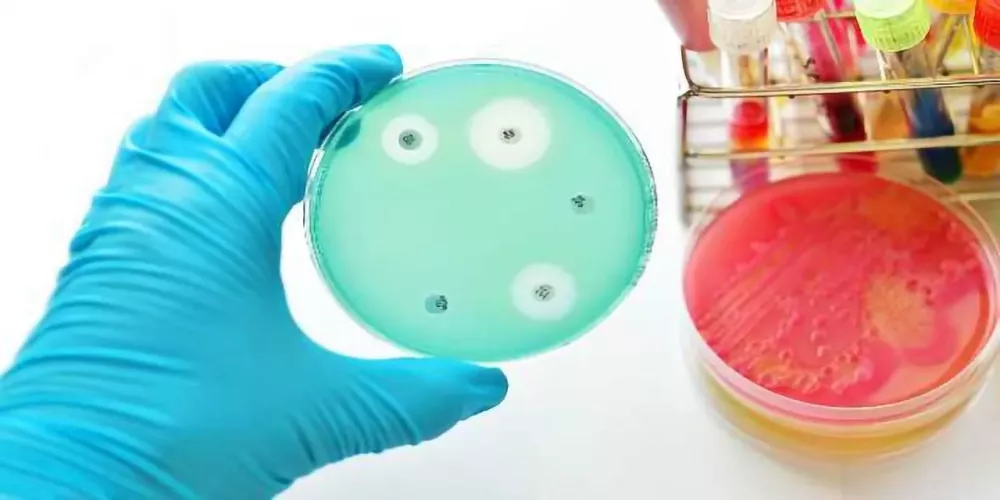

تذوب الأنهار الجليدية بسرعة متزايدة، ولا تقتصر تداعيات ذلك على ارتفاع مستوى سطح البحر أو اختفاء المناظر الطبيعية. إذ يحذر علماء الآن من أن مياه الذوبان قد تحمل معها مادة وراثية خفية تساعد البكتيريا على مقاومة المضادات الحيوية.
وإذا انتشرت هذه الجينات إلى المصبات السفلية، فقد تزيد بهدوء من المخاطر الصحية في المناطق التي تعتمد على المياه المغذاة بالأنهار الجليدية. ويأتي هذا التحذير في مراجعة علمية جديدة قادها باحثون من جامعة لانتشو.
وتشير الورقة إلى أن الأنهار الجليدية قادرة على تخزين جينات مقاومة المضادات الحيوية لفترات طويلة، وأن الذوبان المدفوع بتغير المناخ قد يحول هذا الأرشيف المتجمد إلى مصدر نشط تنتقل منه المقاومة إلى الأنهار والبحيرات.
نُشرت الدراسة في مجلة Biocontaminant.
الأنهار الجليدية تخزن جينات خفية
لطالما اعتُبرت الأنهار الجليدية بيئات نائية ومنعزلة، باردة وفقيرة بالعناصر الغذائية. وهذا التصور هو ما يجعل الفكرة الجديدة مقلقة: فالجليد ليس مجرد ماء متجمد، بل يحتوي أيضًا على حياة مجهرية متجمدة.
وقال المؤلف المشارك للدراسة، جوانان ماو: «لطالما نُظر إلى الأنهار الجليدية على أنها بيئات نقية ومعزولة. وتُظهر مراجعتنا أنها أيضًا أرشيفات وراثية تخزن مقاومة للمضادات الحيوية، وأن الذوبان المدفوع بالمناخ يحول هذه الأرشيفات إلى مصادر نشطة».
والرسالة الأساسية ليست أن الأنهار الجليدية أصبحت «ملوثة» فجأة، بل إنها تحفظ مواد وراثية، من بينها جينات مقاومة، عبر فترات زمنية طويلة. ومع ذوبان الجليد، يمكن لتلك الجينات أن تعود إلى أنظمة بيئية حية.
مقاومة قديمة وليست حديثة فقط
غالبًا ما تُقدَّم مقاومة المضادات الحيوية بوصفها نتاجًا للطب الحديث والزراعة الصناعية. وهذا جزء مهم من القصة، لكنه ليس كاملها.
فالعديد من جينات المقاومة قديمة وطبيعية، إذ تتنافس الكائنات الدقيقة منذ زمن بعيد باستخدام مركبات شبيهة بالمضادات الحيوية. ويمكن للأنهار الجليدية أن تحتجز الكائنات الدقيقة وحمضها النووي في ظروف باردة لآلاف السنين أو أكثر.
ومع ارتفاع درجات الحرارة، قد تطلق مياه الذوبان تلك المواد في أنظمة المياه العذبة التي لم تتعرض لها سابقًا، على الأقل ليس بالطريقة نفسها أو بالحجم نفسه.
الأنهار الجليدية وجينات المقاومة
تجمع المراجعة نتائج من مناطق جليدية متعددة، من بينها القارة القطبية الجنوبية والقطب الشمالي وهضبة التبت. وتشير إلى أن مستويات المقاومة في الأنهار الجليدية أقل عمومًا من البيئات شديدة التلوث.
ومع ذلك، جرى رصد نطاق واسع من جينات المقاومة، بما في ذلك جينات مرتبطة بمضادات حيوية مهمة في الرعاية الطبية.
وتزداد المخاوف عند تتبع مسار المياه. فالأنهار والبحيرات المغذاة بالجليد ليست أنظمة هامشية، بل تمثل مصادر أساسية للمياه لملايين البشر، فضلًا عن الزراعة والحياة البرية.
وقال ماو: «الأنهار والبحيرات المغذاة بالجليد مصادر مياه أساسية لملايين الأشخاص. وبمجرد دخول جينات المقاومة إلى هذه الأنظمة المترابطة، يمكن أن تتفاعل مع بكتيريا حديثة، ما يزيد خطر انتشارها عبر المجتمعات الميكروبية».
ويكمن القلق الرئيس في هذا التفاعل؛ فالجين وحده مجرد معلومة، لكن الخطر يتصاعد عندما تلتقطه بكتيريا قادرة على دمجه ونقله. وفي العالم الميكروبي، يمكن للجينات أن تنتقل بين الكائنات بطرق لا تتطلب تكاثرًا تقليديًا، وهو ما يفسر سرعة انتشار المقاومة عند توافر الظروف.
من الجليد إلى الأنهار
تطرح المراجعة فكرة أن الأنهار الجليدية والأنهار والبحيرات لا ينبغي التعامل معها كبيئات منفصلة. ويقدم الباحثون مفهوم «استمرارية الأنهار الجليدية»، أي سلسلة مترابطة يمكن أن تُنقل عبرها جينات المقاومة وتُعاد صياغتها، بل وقد تتضخم، مع انتقال المياه نحو المصبات.
وقال ماو: «ركزت معظم الدراسات السابقة على موائل منفردة بمعزل عن غيرها. وهذا النهج يغفل كيفية تحرك جينات المقاومة عبر المناظر الطبيعية الحقيقية».
ومع ابتعاد مياه الذوبان عن الجليد، تصبح البيئات أكثر دفئًا وغنىً بالمغذيات، ما يدعم نموًا ميكروبيًا أكبر وفرصًا أوسع لتبادل الجينات. وقد تتحول الأنهار إلى مناطق اختلاط، بينما تعمل البحيرات كمخازن تتراكم فيها الجينات وقد تنتقل عبر الشبكات الغذائية.
عندما تلتقي المقاومة بالضراوة
تحذر المراجعة أيضًا من احتمال أكثر إزعاجًا، وهو تزامن جينات المقاومة مع عوامل الضراوة، وهي السمات الوراثية التي تساعد البكتيريا على إحداث المرض.
ولا يدعي الباحثون أن الأنهار الجليدية تُنتج «بكتيريا خارقة» بذاتها، لكنهم يرون أن إطلاق جينات المقاومة في مجتمعات ميكروبية نشطة قد يزيد احتمالات ظهور تركيبات خطرة، خاصة إذا التقت ببكتيريا تمتلك أصلًا قدرة على إحداث الأمراض.
بصمة بشرية في جليد بعيد
توضح المراجعة أن تغير المناخ ليس العامل الوحيد المؤثر في محتوى البيئات الجليدية. فالأنشطة البشرية يمكن أن تدخل جينات مقاومة حديثة حتى إلى مناطق تبدو بعيدة عن المدن والمستشفيات.
فالتلوث المحمول جوًا قد يقطع مسافات طويلة، والطيور المهاجرة تنقل الميكروبات عبر القارات، كما تضيف السياحة ومحطات الأبحاث مسارات أخرى للتعرض. وتشير المراجعة إلى أن مستويات المقاومة أعلى في بعض مناطق القطب الشمالي مقارنة بالقارة القطبية الجنوبية، وهو ما يُعزى إلى التأثير البشري الأكبر في الشمال.
الأنهار الجليدية ومقاومة المضادات الحيوية
يدعو الباحثون إلى أن تبدأ الاستجابة بأدوات رصد أفضل، من خلال برامج متابعة منسقة تتبع جينات المقاومة على طول المسار الكامل من الجليد إلى الأنهار ثم البحيرات، باستخدام تقنيات مثل التسلسل الجيني الشامل.
كما يدعون إلى أطر إنذار مبكر لتقييم المخاطر البيئية والصحية قبل ترسخ المقاومة في الأنظمة الواقعة في المصبات السفلية.
ويختتم ماو بقوله: «تغير المناخ يعيد تشكيل المخاطر الميكروبية بطرق لا نزال في بدايات فهمها. والاعتراف بالأنهار الجليدية كجزء من مشهد مقاومة المضادات الحيوية العالمي خطوة مهمة لحماية صحة الإنسان والبيئة».